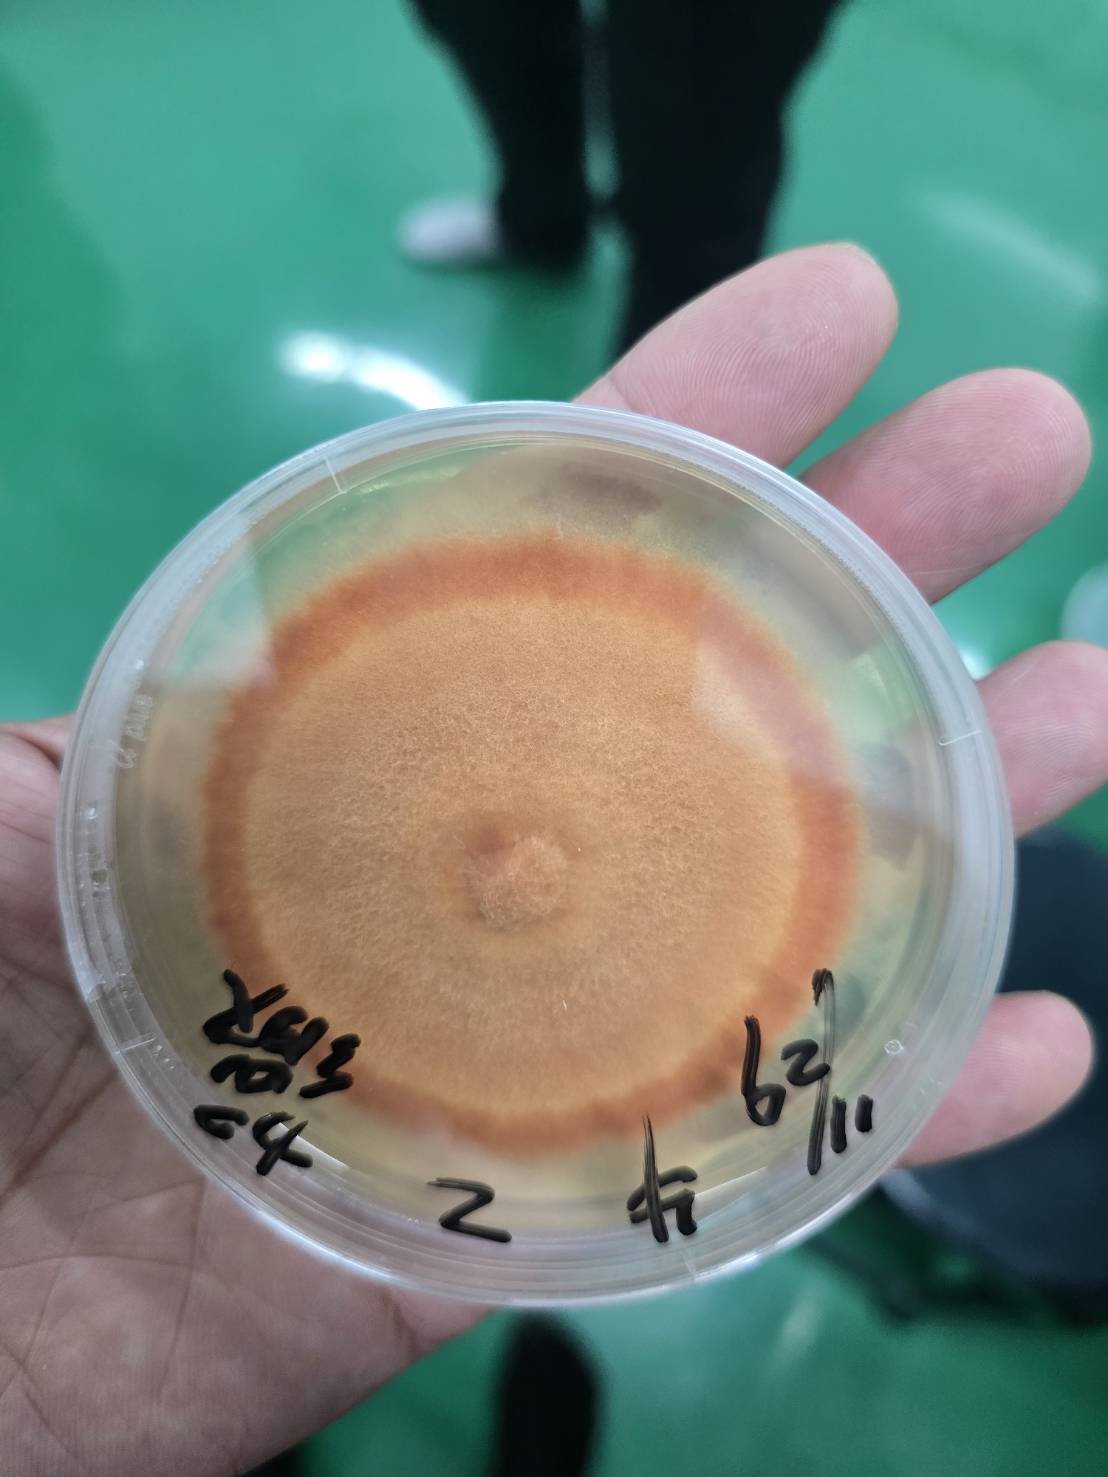

ดร.ภัทร์–พญ.รดา เดินทางสู่เมือง Puli ประเทศไต้หวัน ศึกษาต้นกำเนิดเห็ดยา Antrodia camphorata
วันที่ 5–7 กุมภาพันธ์ 2569
ดร.ภัทร์ หนังสือ และ พญ.รดา หนังสือ ได้เดินทางไปยังเมือง Puli (埔里鎮) ประเทศไต้หวัน ซึ่งเป็นหนึ่งในศูนย์กลาง สำคัญของการเพาะเลี้ยงและวิจัยเห็ดยาระดับโลก โดยเฉพาะเห็ดยาที่มีชื่อเสียงที่สุดของไต้หวัน คือ Antrodia camphorata
การเดินทางครั้งนี้มีวัตถุประสงค์เพื่อศึกษาองค์ความรู้เชิงลึกเกี่ยวกับสายพันธุ์ป่า เทคนิคการเพาะเลี้ยงขั้นสูง การเพิ่มปริมาณสารสำคัญ (bioactive compounds) และการวางแผนความร่วมมือระหว่างประเทศ เพื่อพัฒนาเห็ดยา Antrodia สำหรับผู้ป่วยและผู้มีปัญหาสุขภาพในประเทศไทย
คณะของ ดร.ภัทร์ ได้รับการต้อนรับอย่างอบอุ่นจากคุณ張福坤 (Mr. Chang Fu-Kun) กรรมการ (Board Director) สมาคมเห็ดและเห็ดยา แห่งประเทศไต้หวัน ผู้เชี่ยวชาญด้านการเพาะเลี้ยงเห็ดยาสายพันธุ์ป่า Antrodia
คุณ Chang Fu-Kun ถือเป็นหนึ่งในผู้เชี่ยวชาญแนวหน้าในการเพาะเลี้ยงและอนุรักษ์สายพันธุ์ Antrodia จากแหล่งธรรมชาติ โดยเฉพาะสายพันธุ์ที่เก็บจากป่าต้นน้ำใกล้ทะเลสาบสุริยันจันทรา (Sun Moon Lake) ซึ่งเป็นพื้นที่ที่มีระบบนิเวศเฉพาะตัวและเป็นต้นกำเนิดดั้งเดิม ของเห็ดยาชนิดนี้ การเพาะเลี้ยงบนไม้ Cinnamomum kanehirae การขยายพันธุ์เชื้อบริสุทธิ์ในห้องปฏิบัติการ ในครั้งนี้ ดร.ภัทร์ ได้รับหัวเชื้อ สายพันธุ์ป่าคุณภาพสูงจากแหล่งต้นกำเนิด พร้อมถ่ายทอดเทคนิคการเพาะเลี้ยงเชิงลึกเพื่อเพิ่มสารสำคัญในระดับอุตสาหกรรม
ความร่วมมือเชิงยุทธศาสตร์ไต้หวัน–ไทย ในการหารือครั้งนี้ มีการวางแผน : จัดส่งวัตถุดิบสายพันธุ์ป่าคุณภาพสูงจากไต้หวัน
ถ่ายทอดเทคนิคเพิ่มปริมาณ triterpenoids พัฒนาเป็นวัตถุดิบเกรดคลินิกในประเทศไทย
Antrodia camphorata: เห็ดยาแห่งไต้หวัน ชื่อวิทยาศาสตร์ Antrodia camphorata (M.Zang & C.H.Su) Sheng H.Wu, Ryvarden & T.T.Chang
ชื่อพ้อง: Antrodia cinnamomea อนุกรมวิธาน Kingdom: Fungi Phylum: Basidiomycota Class: Agaricomycetes Order: Polyporales
Family: Fomitopsidaceae เห็ดชนิดนี้เจริญเติบโตเฉพาะบนต้นไม้ Cinnamomum kanehirae ซึ่งเป็นไม้พื้นถิ่นของไต้หวันเท่านั้น ทำให้มีความหายากและมีมูลค่าสูงมาก งานวิจัยมากกว่า 300 ฉบับทั่วโลก: สรุปเชิงลึก Antrodia camphorata ได้รับการศึกษาทางวิทยาศาสตร์ อย่างกว้างขวางในระดับเซลล์ สัตว์ทดลอง และมนุษย์ โดยสรรพคุณหลักที่ได้รับการยืนยัน ได้แก่:
1. ฤทธิ์ต้านมะเร็ง (Anti-Cancer Activity) มะเร็งตับ (Hepatocellular Carcinoma – HCC) ทดสอบในเซลล์ HepG2, Huh7
ค่า IC50 ของสารสกัด triterpenoids อยู่ในช่วงประมาณ 20–100 µg/mL ยับยั้ง NF-κB, STAT3, PI3K/Akt เพิ่ม Bax/Bcl-2 ratio
กระตุ้น Caspase-3 และ Caspase-9 ในสัตว์ทดลองแบบ xenograft model พบว่าสามารถลดขนาดก้อนมะเร็งได้อย่างมีนัยสำคัญ
มะเร็งปอด (Lung Cancer) ศึกษาในเซลล์ A549 และ H1975 IC50 ประมาณ 25–80 µg/mL ลด EGFR และ VEGF ยับยั้ง EMT ลด Snail
ลด Twist ลด Zeb1 ลด MMP-2 และ MMP-9 แสดงศักยภาพในการลดการแพร่กระจายของเซลล์มะเร็ง
2. ฤทธิ์ต้านการอักเสบ Antrodia ลดการสร้าง: TNF-α IL-1β IL-6 COX-2 iNOS ผ่านกลไกยับยั้ง NF-κB และ MAPK pathway
3. ฤทธิ์ปกป้องตับในโมเดลสัตว์ทดลอง: ลด ALT, AST ลด fibrosis ลด oxidative stress เพิ่ม SOD และ GSH
4. ฤทธิ์ต้านอนุมูลอิสระกระตุ้น Nrf2 เพิ่ม HO-1 ลด ROS
5. ความปลอดภัยในมนุษย์ไม่พบพิษต่อตับในขนาด 500–1000 mg/วัน ไม่พบพิษต่อไต LD50 สูงมากในสัตว์ทดลอง